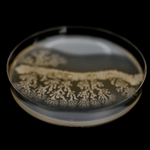
Petri dish showing a cultured probiotic bacterial colony.
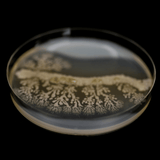
Petri dish showing a cultured probiotic bacterial colony.
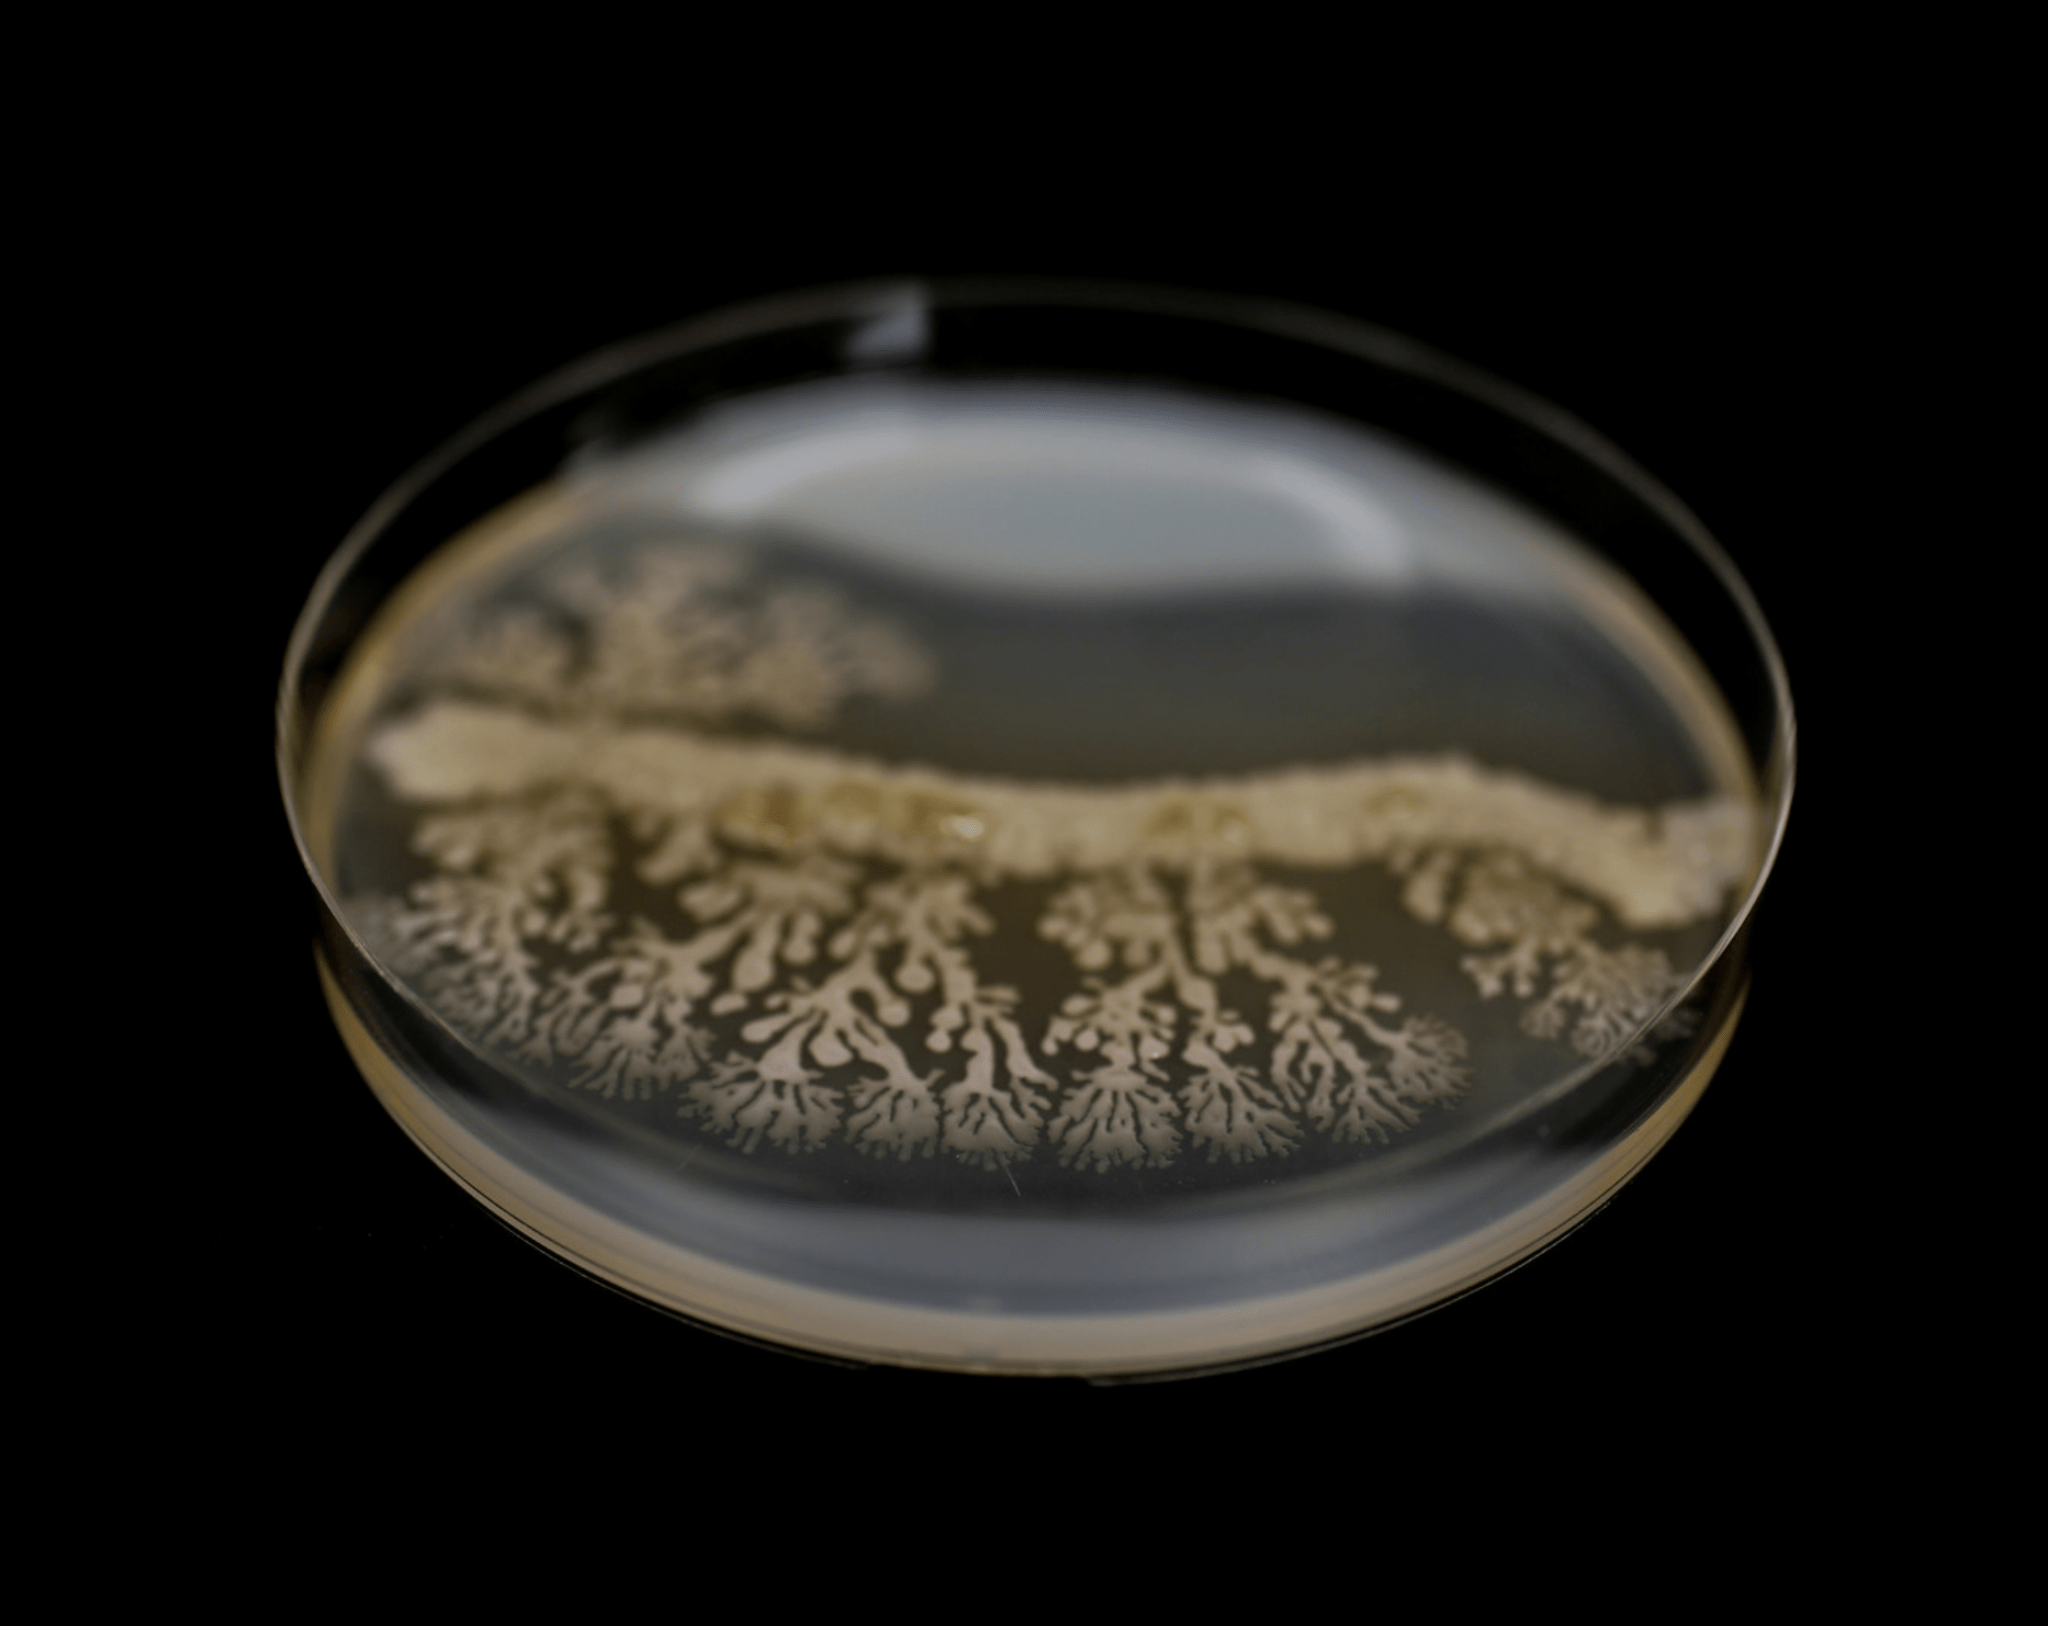
Petri dish showing a cultured probiotic bacterial colony.

Living EM CEO Microbes. Real Results.
RAINFOREST SCIENCE
RESEARCH CONFIRMS
14 Years of Research. One Living Formula.
The microbes in Microbiome Harmonizer come from super old places in nature that are thousands of years old! They’ve been helping people stay healthy for a long time. Work Better Together: These special microbes work together to make your gut health 40-60% stronger than other products.
Reduces Stress by 60%: These microbes can also help fight things that make you feel old and tired by lowering stress in your body by 60%.
Benefits beyond your gut
MICRONUTRIENT SYNTHESIS


“HUMANITY TRANSFORMS WHEN WE RETURN TO OUR ORIGINAL DESIGN.”
Lara Wegener, MD
WE GOT YOU
DO YOU WANT TO UPGRADE YOUR NATURAL ROUTINE?
Questions? We’re here to help.
Are the elixirs suitable for everyone?
Forest in the Bottle elixirs are designed to support individuals who want to actively maintain their vitality, energy, and overall wellbeing. The formulations combine nature-derived ingredients with modern regenerative science, including hand-harvested botanicals from rainforest ecosystems, bioactive compounds, minerals, and other carefully selected nutrients that support the body’s natural balance.
Our elixirs can be integrated into the daily routine of both active individuals and those seeking to support their wellbeing and resilience through natural systems.
If you have any medical condition or are unsure whether the products are suitable for you, we recommend consulting your healthcare professional before use. The products are not recommended for children, pregnant women, or breastfeeding mothers.
Legal Disclaimer:
Dietary supplements should not be used as a substitute for a balanced and varied diet and a healthy lifestyle. Keep out of reach of young children. Do not exceed the recommended daily dose. Intended for adult use only. If you are pregnant, breastfeeding, taking medication, or under medical supervision, consult a healthcare professional before using any dietary supplement.
What is the production process for your elixirs?
All products are sourced from our own cultivation and are handcrafted throughout the entire process. We use CEO microorganisms in the rainforest-treated soil of our fields. This method allows the plants to grow 3 to 6 times larger than the average size, without the use of toxins or fertilizers. As a result, our elixir ingredients are three times more potent than those grown in other soils.
Are the elixirs organic?
Our botanical ingredients used in our elixirs originate from naturally grown plants sourced from the rainforest in Yucatan, Mexico. These ecosystems provide exceptionally rich soil and biodiversity, allowing plants to develop a wide range of naturally occurring bioactive compounds.
Because our formulations combine botanicals, minerals, microorganisms, and specialized extraction processes, not every ingredient can carry a formal organic certification. However, we prioritize clean sourcing, careful cultivation, and strict quality testing to ensure the purity and integrity of every formulation.
Why are the elixirs different from other nutritional supplements?
Most conventional supplements focus on isolated vitamins or single ingredients. Our elixirs follow a systems-based approach to longevity and vitality.
They combine rainforest botanicals, naturally occurring microorganisms, trace minerals, and advanced regenerative science developed through decades of research into ancient ecosystems and natural biological processes. Rather than targeting a single nutrient, the goal is to support the body’s natural balance, energy systems, and long-term resilience.
This unique combination of nature-derived compounds and modern longevity science makes the elixirs fundamentally different from traditional supplements.
When will I notice the benefits?
Every body responds differently, as individual metabolism, lifestyle, and nutritional status can influence how quickly effects are perceived.
Some people report subtle improvements in energy, focus, or overall wellbeing within the first few weeks of consistent use. However, the biological processes our formulations support - such as cellular balance and long-term vitality - typically develop gradually over time.
For optimal results, we recommend incorporating the elixirs into your daily routine consistently for at least 2–3 months. Building a regular routine allows the body to fully benefit from the synergistic combination of botanicals, minerals, and bioactive compounds.
Consistency and a balanced lifestyle play an important role in experiencing the full potential of the formulations. 🌿
Why is it better to purchase a product stock?
Consistency is key when supporting long-term vitality. Maintaining a regular routine allows your body to adapt and benefit from the ingredients over time.
Keeping a small product reserve ensures uninterrupted use and sustained support for your wellbeing routine.
To which countries do you deliver shipments?
We currently ship to customers across the European Union, the United States, and Mexico.
Our products originate from our own cultivation projects in the Mexican rainforest and are quality tested in Germany. Orders are shipped from our logistics centers in Europe and Mexico, allowing us to provide reliable international delivery.
During checkout, you will see the available shipping options, estimated delivery times, and shipping costs based on your location. Faster shipping options may be available depending on the destination.
If your country is not listed as a shipping destination, please contact us at info@mylongevitylife.com and we will gladly explore alternative shipping options for you.
30-Day Money-Back Guarantee
Your satisfaction is important to us. If you are not satisfied with your purchase, we offer a 30-day hassle-free money-back guarantee on first-time orders.
The guarantee is valid within 30 days of your purchase date. While we recommend using the products consistently for at least three months to experience their full benefits, you may request a refund within this period if the product does not meet your expectations.
Simply contact our team through the website and let us know about your experience. We will issue a full refund - no return required.
Where do you source your ingredients from?
Our ingredients are sourced from some of the most biodiverse ecosystems on Earth, with a strong focus on the protected rainforests of Mexico. These ancient environments contain a unique diversity of botanicals, microorganisms, and natural compounds that have evolved over millions of years.
Many of our plant ingredients are hand-harvested in small batches and come from carefully managed rainforest cultivation projects. This approach helps preserve the surrounding ecosystem while allowing us to work with highly potent natural compounds.
We combine this nature-based sourcing with modern regenerative science to create products that support the body’s natural balance and long-term vitality.
Our goal is to unite the intelligence of nature with advanced longevity research, while respecting and protecting the ecosystems from which these ingredients originate. 🌿